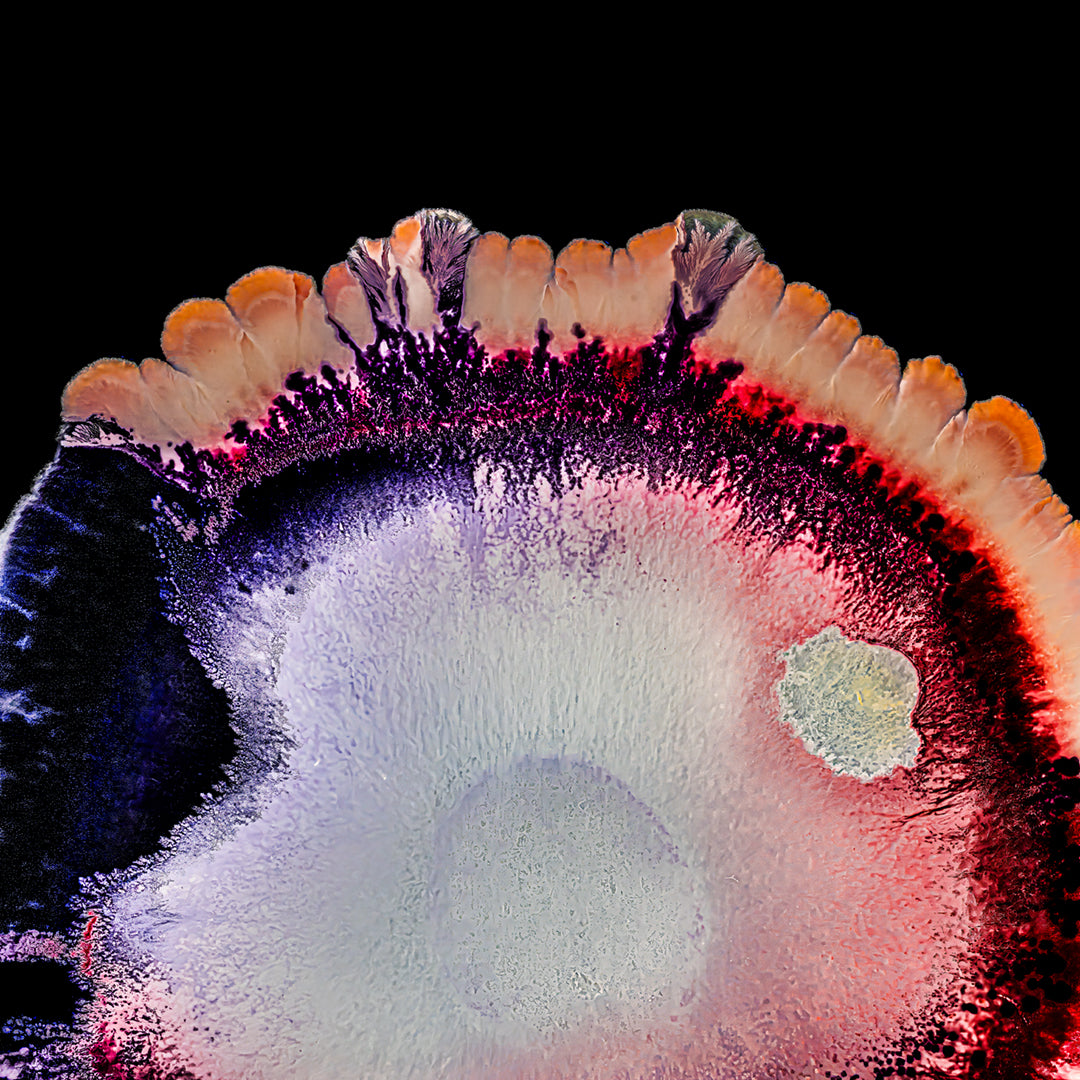
Bacterioästhetik

Ulrich Kallinger
Bacterioästhetik
Bacterioästhetik
Verfügbarkeit für Abholungen konnte nicht geladen werden
Poesie einer uns verborgenen Welt
Einzigartige Makroaufnahmen von lebenden und natürlichen Bakterien. Eine Symbiose zwischen Natur und künstlerischer Gestaltung ist die Bacteriographie. Unsichtbares wird durch kundige Anordnung sichtbar gezielt und gestalterisch eingesetzt und fotografiert. Zusammen mit dem Wiener Bacteriographen, Künstler und Entdecker, Erich Schopf, erstellen wir diese multiorganismische Malkunst von lebenden Bakterien.
Auch erhältlich auf:
Fotoboard, Leinwand, mit und ohne Rahmen, whatever you want, ich freue mich auf eine Nachricht von dir.
Acrylglas: Foto wird auf einer 4 mm starke Acrylglasplatte gedruckt. Mit einer Extraportion Glamour hebt ein Acrylglas-Foto die Farben, Details und Tiefe deiner Lieblingsfotos hervor und lässt sie lebendig wirken. Das robuste Acrylglas schützt dein Foto vor Staub und Kratzern und ist für den Innen- und Außenbereich geeignet.
Aluminium: Foto wird mit einem scharfen Detailfinish auf eine 3 mm starke Aluminiumplatte gedruckt. Es ist sehr stabil und langlebig und auch für den Outdoorbereich geeignet.
Fotoboard: Foto wird auf eine 5 mm starke matte Hartschaumplatte, reflexionsfrei, mit scharfen Details und satten Farben gedruckt, welche die Farben zusätzlich zum Leuchten bringen.
Leinwand: Foto wird auf 100% Polyester gedruckt und auf einen robusten 18-mm-Holzrahmen gespannt. Auch mit hochwertiger Schattenfugen-Rahmen in den Farben, Schwarz, Weiß und Natur in klassischen Look.
Share